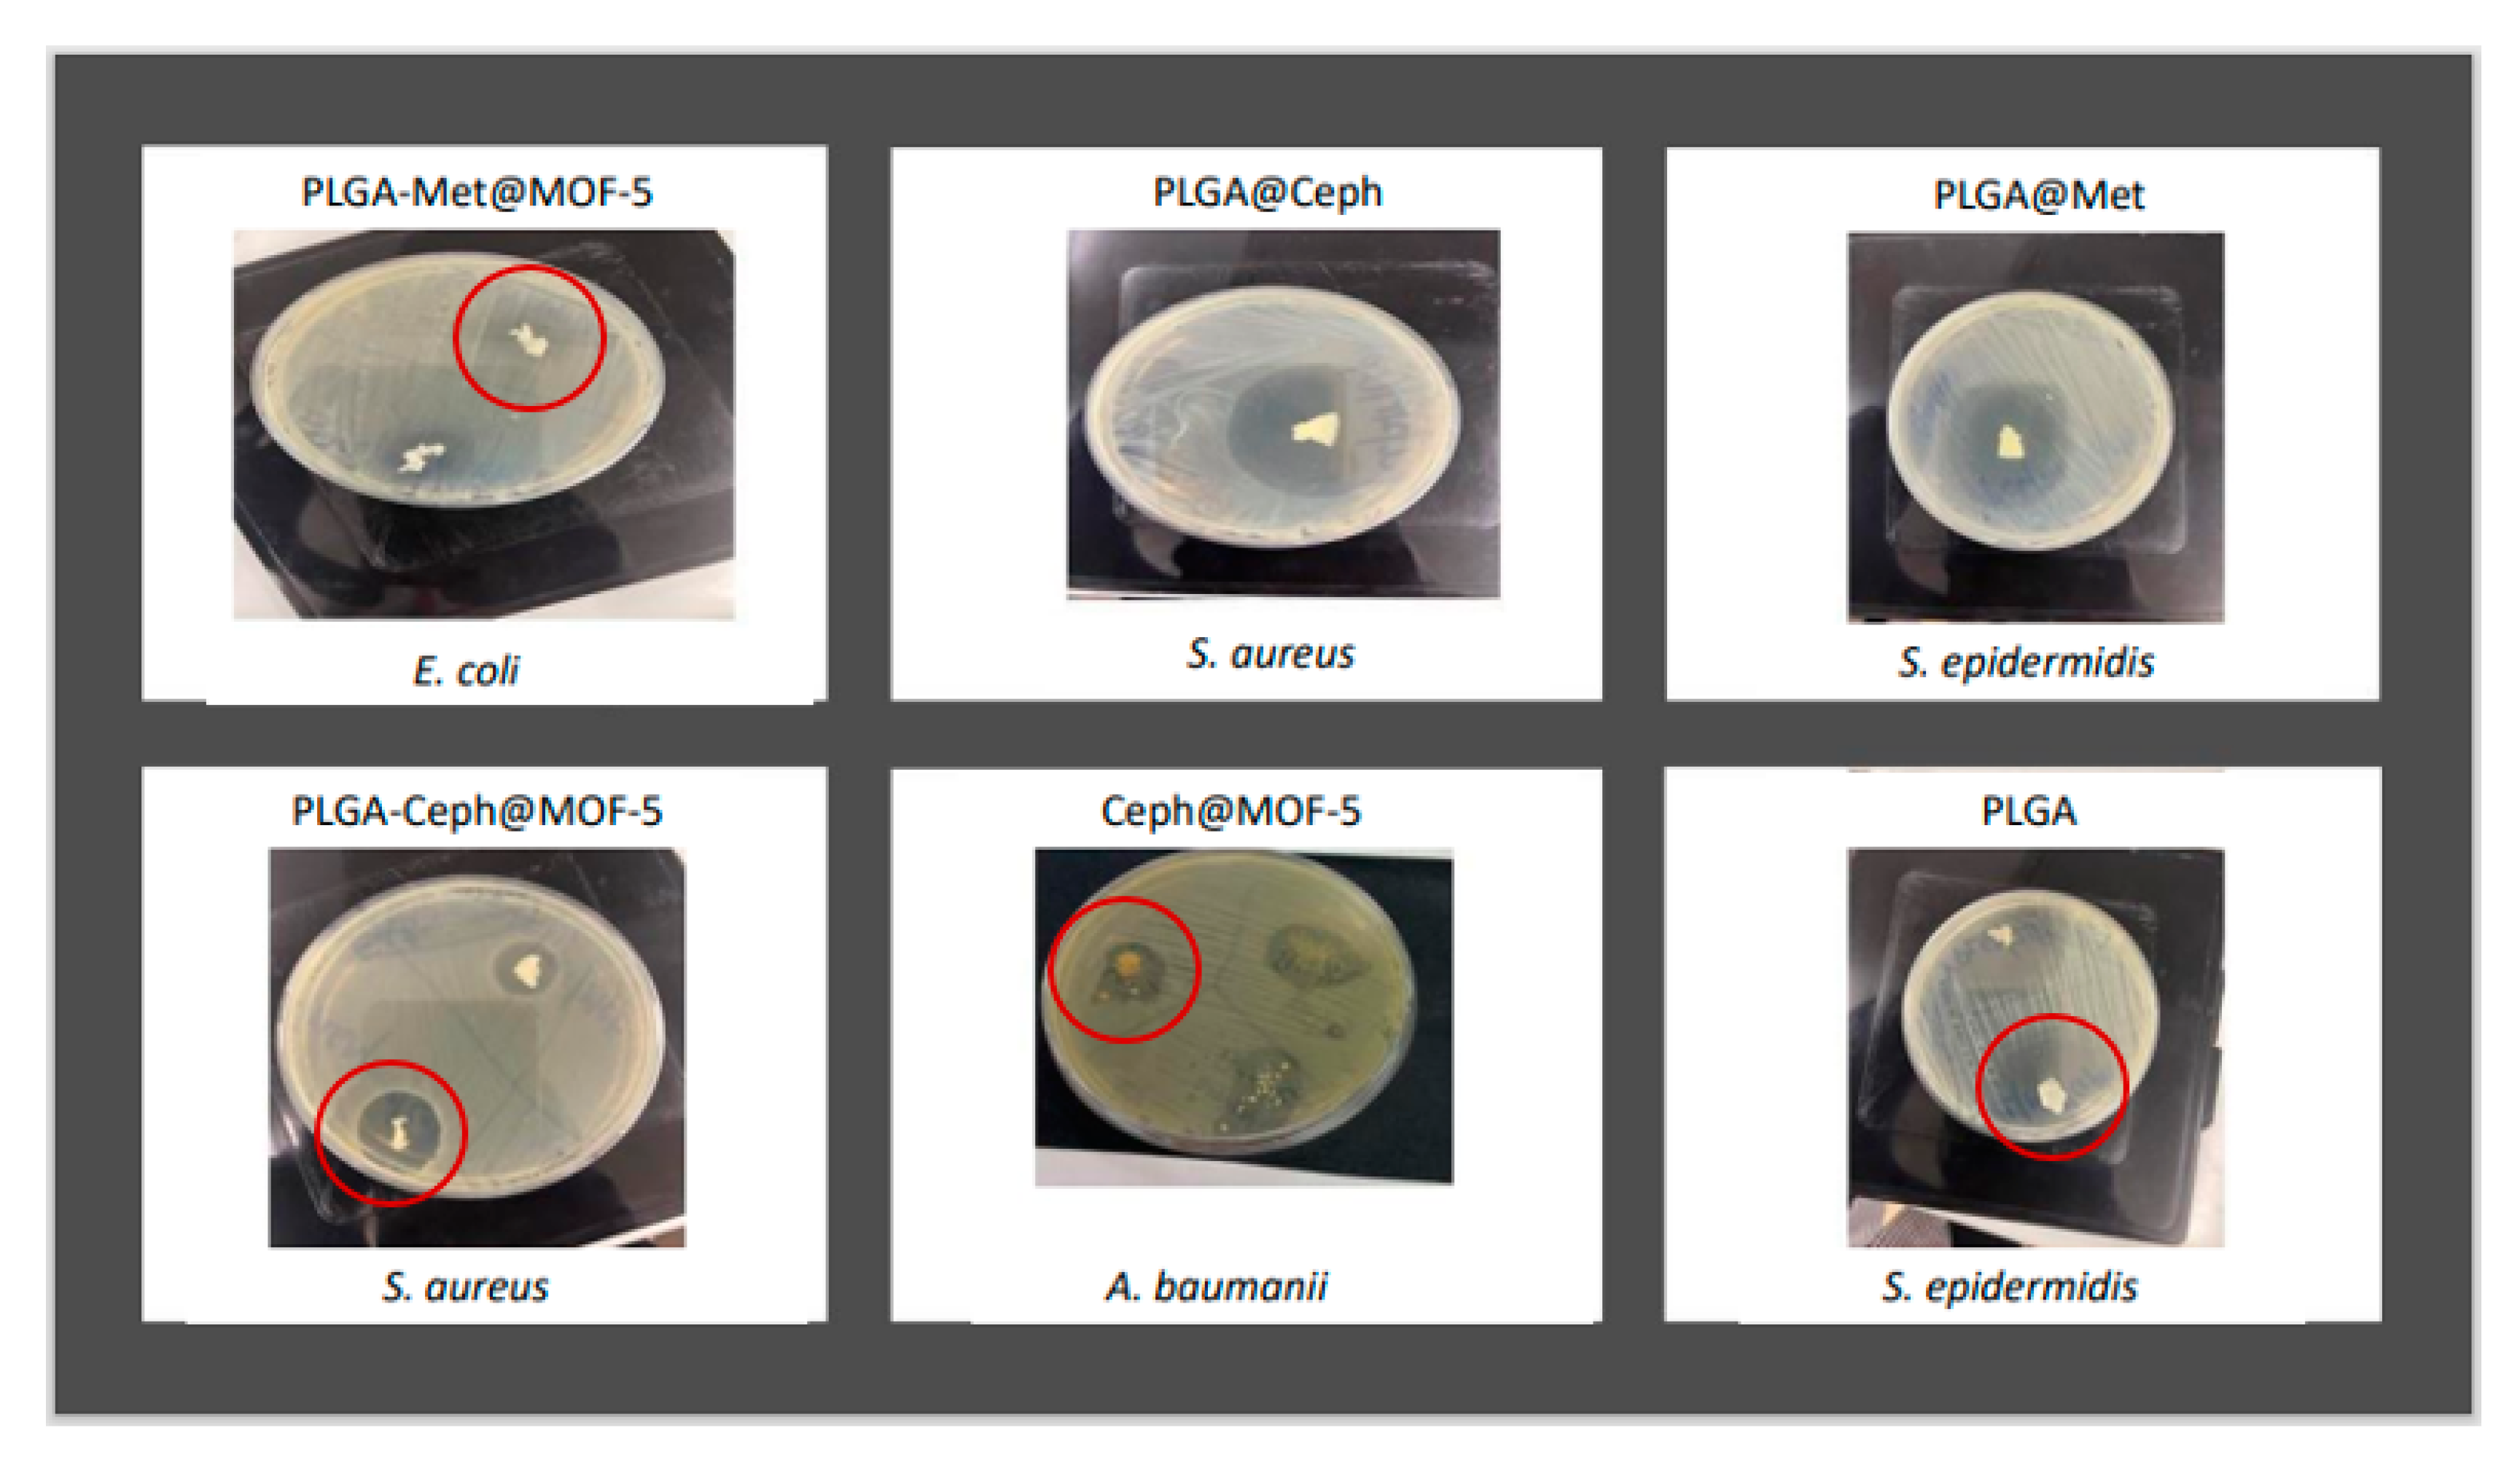
Applsci 13 10611 g009

Biodegradable Polymer Composites of Metal Organic Framework-5 (MOF-5) for the Efficient and Sustained Delivery of Cephalexin and Metronidazole
Abstract
1. Introduction
2. Experimental Section
2.1. Materials Used
2.2. Synthesis
2.2.1. Synthesis of Pristine MOF-5
2.2.2. Activation of MOFs
2.2.3. Post-Synthetic Loading of MOFs (Ceph@MOF-5 and Met@MOF-5)
2.3. Formulation of Polymer Composites (PLGA-Ceph@MOF-5, PLGA-Met@MOF-5, PCL-Met@MOF-5 and PCL-Ceph@MOF-5)
2.4. Material Characterisation
2.5. Drug Release Studies
2.6. Antibacterial Studies
3. Results and Discussion
3.1. PXRD
3.2. SEM
3.3. FT-IR
3.4. TGA
3.5. Drug Release Profile
3.6. Antimicrobial Studies
4. Conclusions
Supplementary Materials
Author Contributions
Funding
Institutional Review Board Statement
Informed Consent Statement
Data Availability Statement
Acknowledgments
Conflicts of Interest
References
- Abushaheen, M.A.; Muzaheed; Fatani, A.J.; Alosaimi, M.; Mansy, W.; George, M.; Acharya, S.; Rathod, S.; Divakar, D.D.; Jhugroo, C.; et al. Antimicrobial resistance, mechanisms and its clinical significance. Dis. Mon. 2020, 66, 100971. [Google Scholar] [CrossRef] [PubMed]
- de Kraker, M.E.A.; Stewardson, A.J.; Harbarth, S. Will 10 Million People Die a Year due to Antimicrobial Resistance by 2050? PLoS Med. 2016, 13, e1002184. [Google Scholar] [CrossRef] [PubMed]
- Seil, J.T.; Webster, T.J. Antimicrobial applications of nanotechnology: Methods and literature. Int. J. Nanomed. 2012, 7, 2767–2781. [Google Scholar] [CrossRef]
- Lu, X.; Ye, J.; Zhang, D.; Xie, R.; Bogale, R.F.; Sun, Y.; Zhao, L.; Zhao, Q.; Ning, G. Silver carboxylate metal–organic frameworks with highly antibacterial activity and biocompatibility. J. Inorg. Biochem. 2014, 138, 114–121. [Google Scholar] [CrossRef] [PubMed]
- Sava Gallis, D.F.; Butler, K.S.; Agola, J.O.; Pearce, C.J.; McBride, A.A. Antibacterial Countermeasures via Metal–Organic Framework-Supported Sustained Therapeutic Release. ACS Appl. Mater. 2019, 11, 7782–7791. [Google Scholar] [CrossRef] [PubMed]
- Rojas, S.; Wheatley, P.S.; Quartapelle-Procopio, E.; Gil, B.; Marszalek, B.; Morris, R.E.; Barea, E. Metal–organic frameworks as potential multi-carriers of drugs. CrystEngComm 2013, 15, 9364–9367. [Google Scholar] [CrossRef]
- Rojas, S.; Quartapelle-Procopio, E.; Carmona, F.J.; Romero, M.A.; Navarro, J.A.R.; Barea, E. Biophysical characterisation, antitumor activity and MOF encapsulation of a half-sandwich ruthenium(ii) mitoxantronato system. J. Mater. Chem. B 2014, 2, 2473–2477. [Google Scholar] [CrossRef]
- Sun, T.; Zhang, Y.S.; Pang, B.; Hyun, D.C.; Yang, M.; Xia, Y. Engineered Nanoparticles for Drug Delivery in Cancer Therapy. Angew. Chem. Int. Ed. 2014, 53, 12320–12364. [Google Scholar] [CrossRef]
- Abdelaziz, H.M.; Gaber, M.; Abd-Elwakil, M.M.; Mabrouk, M.T.; Elgohary, M.M.; Kamel, N.M.; Kabary, D.M.; Freag, M.S.; Samaha, M.W.; Mortada, S.M.; et al. Inhalable particulate drug delivery systems for lung cancer therapy: Nanoparticles, microparticles, nanocomposites and nanoaggregates. J. Control Release 2018, 269, 374–392. [Google Scholar] [CrossRef]
- Wuttke, S.; Lismont, M.; Escudero, A.; Rungtaweevoranit, B.; Parak, W.J. Positioning metal-organic framework nanoparticles within the context of drug delivery—A comparison with mesoporous silica nanoparticles and dendrimers. Biomaterials 2017, 123, 172–183. [Google Scholar] [CrossRef]
- Livesey, T.C.; Mahmoud, L.A.M.; Katsikogianni, M.G.; Nayak, S. Metal–Organic Frameworks and Their Biodegradable Composites for Controlled Delivery of Antimicrobial Drugs. Pharmaceutics 2023, 15, 274. [Google Scholar] [PubMed]
- Mallakpour, S.; Nikkhoo, E.; Hussain, C.M. Application of MOF materials as drug delivery systems for cancer therapy and dermal treatment. Coord. Chem. Rev. 2022, 451, 214262. [Google Scholar] [CrossRef]
- Batten, S.R.; Champness, N.R.; Chen, X.-M.; Garcia-Martinez, J.; Kitagawa, S.; Öhrström, L.; O’Keeffe, M.; Suh, M.P.; Reedijk, J. Terminology of metal–organic frameworks and coordination polymers (IUPAC Recommendations 2013). Pure Appl. Chem. 2013, 85, 1715–1724. [Google Scholar] [CrossRef]
- Cui, Y.; Yue, Y.; Qian, G.; Chen, B. Luminescent Functional Metal–Organic Frameworks. Chem. Rev. 2012, 112, 1126–1162. [Google Scholar] [CrossRef]
- Zheng, H.; Zhang, Y.; Liu, L.; Wan, W.; Guo, P.; Nyström, A.M.; Zou, X. One-pot Synthesis of Metal–Organic Frameworks with Encapsulated Target Molecules and Their Applications for Controlled Drug Delivery. J. Am. Chem. Soc. 2016, 138, 962–968. [Google Scholar] [CrossRef]
- Chen, S.; Lu, J.; You, T.; Sun, D. Metal-organic frameworks for improving wound healing. Coord. Chem. Rev. 2021, 439, 213929. [Google Scholar] [CrossRef]
- Xie, J.; Wang, Y.; Liu, W.; Yin, X.; Chen, L.; Zou, Y.; Diwu, J.; Chai, Z.; Albrecht-Schmitt, T.E.; Liu, G.; et al. Highly Sensitive Detection of Ionizing Radiations by a Photoluminescent Uranyl Organic Framework. Angew. Chem. Int. Ed. 2017, 56, 7500–7504. [Google Scholar] [CrossRef] [PubMed]
- Wang, C.; Liu, X.; Chen, J.P.; Li, K. Superior removal of arsenic from water with zirconium metal-organic framework UiO-66. Sci. Rep. 2015, 5, 16613. [Google Scholar] [CrossRef]
- Rocha, J.; Carlos, L.D.; Paz, F.A.A.; Ananias, D. Luminescent multifunctional lanthanides-based metal-organic frameworks. Chem. Soc. Rev. 2011, 40, 926–940. [Google Scholar] [CrossRef]
- Nandi, S.; Singh, S.K.; Mullangi, D.; Illathvalappil, R.; George, L.; Vinod, C.P.; Kurungot, S.; Vaidhyanathan, R. Low Band Gap Benzimidazole COF Supported Ni3N as Highly Active OER Catalyst. Adv. Energy Mater. 2016, 6, 1601189. [Google Scholar] [CrossRef]
- Mullangi, D.; Chakraborty, D.; Pradeep, A.; Koshti, V.; Vinod, C.P.; Panja, S.; Nair, S.; Vaidhyanathan, R. Highly Stable COF-Supported Co/Co(OH)2 Nanoparticles Heterogeneous Catalyst for Reduction of Nitrile/Nitro Compounds under Mild Conditions. Small 2018, 14, 1801233. [Google Scholar] [CrossRef] [PubMed]
- Mullangi, D.; Dhavale, V.; Shalini, S.; Nandi, S.; Collins, S.; Woo, T.; Kurungot, S.; Vaidhyanathan, R. Low-Overpotential Electrocatalytic Water Splitting with Noble-Metal-Free Nanoparticles Supported in a sp3 N-Rich Flexible COF. Adv. Energy Mater. 2016, 6, 1600110. [Google Scholar] [CrossRef]
- Aden, S.F.; Mahmoud, L.A.M.; Ivanovska, E.H.; Terry, L.R.; Ting, V.P.; Katsikogianni, M.G.; Nayak, S. Controlled delivery of ciprofloxacin using zirconium-based MOFs and poly-caprolactone composites. J. Drug Deliv. Sci. Technol. 2023, 88, 104894. [Google Scholar] [CrossRef]
- Aguado, S.; Quirós, J.; Canivet, J.; Farrusseng, D.; Boltes, K.; Rosal, R. Antimicrobial activity of cobalt imidazolate metal–organic frameworks. Chemosphere 2014, 113, 188–192. [Google Scholar] [CrossRef] [PubMed]
- Nabipour, H.; Sadr, M.H.; Bardajee, G.R. Synthesis and characterization of nanoscale zeolitic imidazolate frameworks with ciprofloxacin and their applications as antimicrobial agents. New J. Chem. 2017, 41, 7364–7737. [Google Scholar] [CrossRef]
- Tenover, F.C. Mechanisms of antimicrobial resistance in bacteria. Am. J. Infect. Control 2006, 34, S3. [Google Scholar] [CrossRef]
- Cai, W.; Wang, J.; Chu, C.; Chen, W.; Wu, C.; Liu, G. Metal–Organic Framework-Based Stimuli-Responsive Systems for Drug Delivery. Adv. Sci. 2019, 6, 1801526. [Google Scholar] [CrossRef]
- Murphy, M.; Ting, K.; Zhang, X.; Soo, C.; Zheng, Z. Current Development of Silver Nanoparticle Preparation, Investigation, and Application in the Field of Medicine. J. Nanomater. 2015, 2015, 696918. [Google Scholar] [CrossRef]
- McKinlay, A.C.; Morris, R.E.; Horcajada, P.; Férey, G.; Gref, R.; Couvreur, P.; Serre, C. BioMOFs: Metal-Organic Frameworks for Biological and Medical Applications. Angew. Chem. Int. Ed. 2010, 49, 6260–6266. [Google Scholar] [CrossRef]
- Li, H.; Eddaoudi, M.; O’Keeffe, M.; Yaghi, O.M. Design and synthesis of an exceptionally stable and highly porous metal-organic framework. Nature 1999, 402, 276. [Google Scholar] [CrossRef]
- Mahmoud, L.A.M.; Telford, R.; Livesey, T.C.; Katsikogianni, M.; Kelly, A.L.; Terry, L.R.; Ting, V.P.; Nayak, S. Zirconium-Based MOFs and Their Biodegradable Polymer Composites for Controlled and Sustainable Delivery of Herbicides. ACS Appl. Bio Mater. 2022, 5, 3972–3981. [Google Scholar] [CrossRef] [PubMed]
- Lan, A.; Li, K.; Wu, H.; Olson, D.H.; Emge, T.J.; Ki, W.; Hong, M.; Li, J. Luminescent Microporous Metal-Organic Framework for the Fast and Reversible Detection of High Explosives. Angew. Chem. Int. Ed. 2009, 48, 2334–2338. [Google Scholar] [CrossRef] [PubMed]
- Dwivedi, R.; Kumar, S.; Pandey, R.; Mahajan, A.; Nandana, D.; Katti, D.S.; Mehrotra, D. Polycaprolactone as biomaterial for bone scaffolds: Review of literature. J. Oral. Biol. Craniofac Res. 2020, 10, 381–388. [Google Scholar] [CrossRef]
- Christen, M.-O.; Vercesi, F. Polycaprolactone: How a Well-Known and Futuristic Polymer Has Become an Innovative Collagen-Stimulator in Esthetics. Clin. Cosmet. Investig. Dermatol. 2020, 13, 31–48. [Google Scholar] [CrossRef] [PubMed]
- Jiang, W.; Gupta, R.K.; Deshpande, M.C.; Schwendeman, S.P. Biodegradable poly(lactic-co-glycolic acid) microparticles for injectable delivery of vaccine antigens. Adv. Drug Deliv. Rev. 2005, 57, 391–410. [Google Scholar] [CrossRef]
- Dziadek, M.; Dziadek, K.; Checinska, K.; Salagierski, S.; Choinska, E.; Szatkowski, P.; Wajda, A.; Kopec, A.; Cholewa-Kowalska, K. Polyphenolic compounds affect the long-term degradation behaviour of polymer and composite materials based on PCL, PLGA, and bioactive glass. Sustain. Mater. Technol. 2023, 35, e00568. [Google Scholar] [CrossRef]
- Engelberg, I.; Kohn, J. Physico-mechanical properties of degradable polymers used in medical applications: A comparative study. Biomaterials 1991, 12, 292–304. [Google Scholar] [CrossRef]
- Kumar, G.; Masram, D.T. Sustainable Synthesis of MOF-5@GO Nanocomposites for Efficient Removal of Rhodamine B from Water. ACS Omega 2021, 6, 9587–9599. [Google Scholar] [CrossRef]
- Baptista, P.V.; McCusker, M.P.; Carvalho, A.; Ferreira, D.A.; Mohan, N.M.; Martins, M.; Fernandes, A.R. Nano-Strategies to Fight Multidrug Resistant Bacteria-“A Battle of the Titans”. Front. Microbiol. 2018, 9, 1441. [Google Scholar] [CrossRef]
- Zapata, A.; Ramirez-Arcos, S. A Comparative Study of McFarland Turbidity Standards and the Densimat Photometer to Determine Bacterial Cell Density. Curr. Microbiol. 2015, 70, 907–909. [Google Scholar] [CrossRef]
- Hafizovic, J.; Bjørgen, M.; Olsbye, U.; Dietzel, P.D.C.; Bordiga, S.; Prestipino, C.; Lamberti, C.; Lillerud, K.P. The Inconsistency in Adsorption Properties and Powder XRD Data of MOF-5 Is Rationalized by Framework Interpenetration and the Presence of Organic and Inorganic Species in the Nanocavities. J. Am. Chem. Soc. 2007, 129, 3612–3620. [Google Scholar] [CrossRef] [PubMed]
- Colin McKinstry, C.; Cathcart, R.J.; Cussen, E.J.; Fletcher, A.J.; Patwardhan, S.V.; Sefcik, J. Scalable continuous solvothermal synthesis of metal organic framework (MOF-5) crystals. Chem. Eng. J. 2016, 285, 718. [Google Scholar] [CrossRef]
- Cao, J.; Guo, C.; Chen, Z. Loading and release mechanisms of MOF-5@BTA-X (X=-CH3/-NH2/-CO(CH2)6CH3): Experimental and theoretical investigations. Colloids Surf. A Physicochem. Eng. Asp. 2023, 666, 131274. [Google Scholar] [CrossRef]
- Arjmandi, M.; Altaee, A.; Arjmandi, A.; Pourafshari Chenar, M.; Peyravi, M.; Jahanshahi, M. A facile and efficient approach to increase the magnetic property of MOF-5. Solid. State Sci. 2020, 106, 106292. [Google Scholar] [CrossRef]
- Mohammadpour, Z.; Zare, H.R. The role of embedded 2-ABT@Cu-BTC MOF on the anti-corrosion performance of electro-assisted deposited silica sol-gel composite film. Mater. Chem. Phys. 2021, 267, 124590. [Google Scholar] [CrossRef]
- Bennabi, S.; Belbachir, M. Synthesis and Characterization of New Organometallic Hybrid Material LCP-1 Based on MOF (Metal–Organic Framework) and Maghnite-H+, a Protons Exchanged Montmorillonite Clay, as Catalytic Support. J. Inorg. Organomet. Polym. Mater. 2017, 27, 1787–1799. [Google Scholar] [CrossRef]
- Ramukutty, S.; Ramachandran, E. Crystal growth by solvent evaporation and characterization of metronidazole. J. Cryst. Growth 2012, 351, 47–50. [Google Scholar] [CrossRef]
- Steckiewicz, K.P.; Cieciórski, P.; Barcińska, E.; Jaśkiewicz, M.; Narajczyk, M.; Bauer, M.; Kamysz, W.; Megiel, E.; Inkielewicz-Stepniak, I. Silver Nanoparticles as Chlorhexidine and Metronidazole Drug Delivery Platforms: Their Potential Use in Treating Periodontitis. Int. J. Nanomed. 2022, 17, 495. [Google Scholar] [CrossRef]
- Minecka, A.; Tarnacka, M.; Jurkiewicz, K.; Hachuła, B.; Wrzalik, R.; Bródka, A.; Kamiński, K.; Kamińska, E. The impact of the size of acetylated cyclodextrin on the stability of amorphous metronidazole. Int. J. Pharm. 2022, 624, 122025. [Google Scholar] [CrossRef]
- Tang, Z.G.; Callaghan, J.T.; Hunt, J.A. The physical properties and response of osteoblasts to solution cast films of PLGA doped polycaprolactone. Biomaterials 2005, 26, 6618–6624. [Google Scholar] [CrossRef]
- Talelli, M.; Rijcken, C.J.F.; Lammers, T.; Seevinck, P.R.; Storm, G.; van Nostrum, C.F.; Hennink, W.E. Superparamagnetic Iron Oxide Nanoparticles Encapsulated in Biodegradable Thermosensitive Polymeric Micelles: Toward a Targeted Nanomedicine Suitable for Image-Guided Drug Delivery. Langmuir 2009, 25, 2060–2067. [Google Scholar] [CrossRef] [PubMed]
- Sevim, K. Modelling of Drug Release from Biodegradable Polymers; University of Leicester: Leicester, UK, 2017. [Google Scholar]
- Pitt, G.G.; Gratzl, M.M.; Kimmel, G.L.; Surles, J.; Sohindler, A. Aliphatic polyesters II. The degradation of poly (DL-lactide), poly (ε-caprolactone), and their copolymers in vivo. Biomaterials 1981, 2, 215–220. [Google Scholar] [CrossRef] [PubMed]
- Tang, Z.G.; Rhodes, N.P.; Hunt, J.A. Control of the Domain Microstructures of PLGA and PCL Binary Systems: Importance of Morphology in Controlled Drug Release. Chem. Eng. Res. Des. 2007, 85, 1044–1050. [Google Scholar] [CrossRef][Green Version]
- Haynes, A.S.; Prinzi, A.; Silveira, L.J.; Parker, S.K.; Lampe, J.N.; Kavanaugh, J.S.; Horswill, A.R.; Fish, D. Cefadroxil Comparable to Cephalexin: Minimum Inhibitory Concentrations among Methicillin-Susceptible Staphylococcus aureus Isolates from Pediatric Musculoskeletal Infections. Microbiol. Spectr. 2022, 10, e01039-22. [Google Scholar] [CrossRef]
- Dione, N.; Khelaifia, S.; Lagier, J.-C.; Raoult, D. The aerobic activity of metronidazole against anaerobic bacteria. Int. J. Antimicrob. Agents 2015, 45, 537–540. [Google Scholar] [CrossRef]
- Brook, I.; Long, S.S. 187-Anaerobic Bacteria: Classification, Normal Flora, and Clinical Concepts. In Principles and Practice of Pediatric Infectious Diseases, 5th ed.; Long, S.S., Prober, C.G., Fischer, M., Eds.; Elsevier: Berlin/Heidelberg, Germany, 2018; pp. 987–995.e982. [Google Scholar]
- Kumar, G.; Kant, A.; Kumar, M.; Masram, D.T. Synthesis, characterizations and kinetic study of metal organic framework nanocomposite excipient used as extended release delivery vehicle for an antibiotic drug. Inorganica Chim. Acta 2019, 496, 119036. [Google Scholar] [CrossRef]
- Kumar, G.; Chaudhary, K.; Mogha, N.K.; Kant, A.; Masram, D.T. Extended Release of Metronidazole Drug Using Chitosan/Graphene Oxide Bionanocomposite Beads as the Drug Carrier. ACS Omega 2021, 6, 20433–20444. [Google Scholar] [CrossRef] [PubMed]
- Lajevardi, A.; Sadr, M.H.; Yaraki, M.T.; Badiei, A.; Armaghan, M. A pH-responsive and magnetic Fe3O4@silica@MIL-100(Fe)/beta-CD nanocomposite as a drug nanocarrier: Loading and release study of cephalexin. New J. Chem. 2018, 42, 9690–9701. [Google Scholar] [CrossRef]
- Murugapandian, R.; Clement, S.; Uthirapathy, V. Fabrication and In Vitro Drug Delivery Evaluation of Cephalexin Monohydrate-Loaded PLA:PVA/HAP:TiO2 Fibrous Scaffolds for Bone Regeneration. ACS Omega 2023, 8, 5017–5032. [Google Scholar] [CrossRef]
- Russell, D.L.; Uslan, D.Z.; Rubin, Z.A.; Grogan, T.R.; Martin, E.M. Multidrug Resistant Acinetobacter baumanii: A 15-Year Trend Analysis. Infect. Control Hosp. Epidemiol. 2018, 39, 608–611. [Google Scholar] [CrossRef]
- Alzayn, M.; Dulyayangkul, P.; Satapoomin, N.; Heesom, K.J.; Avison, M.B. OmpF Downregulation Mediated by Sigma E or OmpR Activation Confers Cefalexin Resistance in Escherichia coli in the Absence of Acquired β-Lactamases. Antimicrob. Agents Chemother. 2021, 65, e01004-21. [Google Scholar] [CrossRef] [PubMed]
- Japoni, A.; Ziyaeyan, M.; Jmalidoust, M.; Farshad, S.; Alborzi, A.; Rafaatpour, N.; Badiee, P. Antibacterial susceptibility patterns and cross-resistance of methicillin resistant and sensitive Staphyloccus aureus isolated from the hospitalized patients in Shiraz, Iran. Braz. J. Microbiol. 2010, 41, 567–573. [Google Scholar] [CrossRef] [PubMed][Green Version]
- Ramukutty, S.; Jeyasudha, R.; Ramachandran, E. Mechanical and thermal studies of metronidazole crystals. Ind. J. Phys. 2013, 87, 1001–1004. [Google Scholar] [CrossRef]
- Pielichowski, K.; Majka, T.M. Polymer Composites with Functionalized Nanoparticles: Synthesis, Properties, and Applications; Elsevier: Amsterdam, The Netherlands, 2019. [Google Scholar]
- Burke, T.L.; Rupp, M.E.; Fey, P.D. Staphylococcus epidermidis. Trends Microbiol. 2023, 31, 763–764. [Google Scholar] [CrossRef]
- Ramia, N.F.; Tang, L.; Cocozaki, A.I.; Li, H. Staphylococcus epidermidis Csm1 is a 3′-5′ exonuclease. Nucleic Acids Res. 2014, 42, 1129–1138. [Google Scholar] [CrossRef]
- Lewicki, M.; Kozioł, M.; Lorenc, K.; Kozioł, M.; Pawlicki, M.; Smoleń, A. Citrobacter freundii and Acinetobacter baumanii infection in a patient with neoplastic lung disease—Case report. Ann. Agric. Environ. Med. 2021, 28, 724–728. [Google Scholar] [CrossRef]
- Laborel-Préneron, E.; Bianchi, P.; Boralevi, F.; Lehours, P.; Fraysse, F.; Morice-Picard, F.; Sugai, M.; Sato’o, Y.; Badiou, C.; Lina, G.; et al. Effects of the Staphylococcus aureus and Staphylococcus epidermidis Secretomes Isolated from the Skin Microbiota of Atopic Children on CD4+ T Cell Activation. PLoS ONE 2015, 10, e0141067. [Google Scholar] [CrossRef]

| Inhibition Zone (mm) | ||||
|---|---|---|---|---|
| S. epidermidis | S. aureus | E. coli | A. baumanii | |
| Pristine MOF-5 | 26 ± 1.5 | 28 ± 0 | 13 ± 1.1 | 13 ± 0.5 |
| PLGA | 51 ± 1.5 | - | - | - |
| PCL | - | - | - | - |
| Inhibition Zone (mm) | ||||
|---|---|---|---|---|
| S. epidermidis | S. aureus | E. coli | A. baumanii | |
| Met | 23 ± 0.5 | 20 ± 0.5 | 13 ± 0.5 | 18 ± 0.5 |
| met@MOF-5 | 21 ± 0.5 | 15 ± 0 | 10 ± 0 | 10 ± 0 |
| met@PLGA | 43 ± 1 | - | - | - |
| met@PCL | 5 ± 1 | - | - | - |
| MOF-5@PLGA | 73 ± 1.5 | 83 ± 0 | - | - |
| MOF5@PCL PLGA-met@MOF-5 PCL-met@MOF-5 | - | - | - | - |
| Inhibition Zone (mm) | ||||
|---|---|---|---|---|
| S. epidermidis | S. aureus | E. coli | A. baumanii | |
| Ceph | 79 ± 1 | 66 ± 1 | 34 ± 0.5 | - |
| ceph@MOF-5 | 34 ± 0.5 | 31 ± 1.5 | 10 ± 0 | 13 ± 0.5 |
| ceph@PLGA | 73 ± 0.5 | 42 ± 0.5 | 25 ± 1 | - |
| ceph@PCL | 16 ± 0 | 32 ± 0.5 | 16 ± 0 | - |
| PLGA-ceph@MOF-5 | 75 ± 0 | 7 ± 0 | - | - |
| PCL-ceph@MOF-5 | 6 ± 0.5 | 11 ± 1 | - | - |
Disclaimer/Publisher’s Note: The statements, opinions and data contained in all publications are solely those of the individual author(s) and contributor(s) and not of MDPI and/or the editor(s). MDPI and/or the editor(s) disclaim responsibility for any injury to people or property resulting from any ideas, methods, instructions or products referred to in the content. |
© 2023 by the authors. Licensee MDPI, Basel, Switzerland. This article is an open access article distributed under the terms and conditions of the Creative Commons Attribution (CC BY) license (https://creativecommons.org/licenses/by/4.0/).
Share and Cite
Anim, A.; Mahmoud, L.A.M.; Kelly, A.L.; Katsikogianni, M.G.; Nayak, S. Biodegradable Polymer Composites of Metal Organic Framework-5 (MOF-5) for the Efficient and Sustained Delivery of Cephalexin and Metronidazole. Appl. Sci. 2023, 13, 10611. https://doi.org/10.3390/app131910611
Anim A, Mahmoud LAM, Kelly AL, Katsikogianni MG, Nayak S. Biodegradable Polymer Composites of Metal Organic Framework-5 (MOF-5) for the Efficient and Sustained Delivery of Cephalexin and Metronidazole. Applied Sciences. 2023; 13(19):10611. https://doi.org/10.3390/app131910611
Chicago/Turabian StyleAnim, Anoff, Lila A. M. Mahmoud, Adrian L. Kelly, Maria G. Katsikogianni, and Sanjit Nayak. 2023. "Biodegradable Polymer Composites of Metal Organic Framework-5 (MOF-5) for the Efficient and Sustained Delivery of Cephalexin and Metronidazole" Applied Sciences 13, no. 19: 10611. https://doi.org/10.3390/app131910611
APA StyleAnim, A., Mahmoud, L. A. M., Kelly, A. L., Katsikogianni, M. G., & Nayak, S. (2023). Biodegradable Polymer Composites of Metal Organic Framework-5 (MOF-5) for the Efficient and Sustained Delivery of Cephalexin and Metronidazole. Applied Sciences, 13(19), 10611. https://doi.org/10.3390/app131910611

